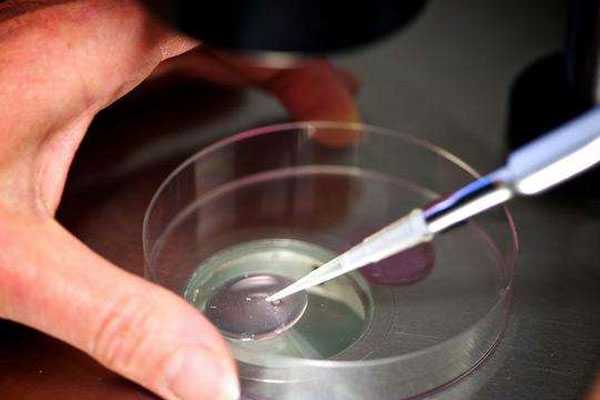

影立试管机构
试管代生收费:阴道出血是试管婴儿移植失败前兆吗?
2025-12-02 阅读 136次试管冻胚移植后很多准妈妈对于自身发生的一些变化异常关注,尤其发现自己阴道出血了总认为是移植失败了,这时候难免非常担心,因此这里来看看冻胚移植失败了有哪些表现吧!

阴道出血暗示移植失败了吗
阴道出血是试管婴儿移植失败前兆吗?
移植后很多女性朋友都比较关心自身的一些症状,尤其当发现自己有出血症状时就会异常紧张起来,认为移植后出血就等于玩完了,其实移植后出血不一定就失败。
移植后轻微出血是正常的
其实出血是移植后常见的现象,有时候轻微的出血是正常的。这时准妈妈在移植后阴道出血,首先是不要慌张,应根据移植天数,从容分析与判断出血的原因,并及时将情况报告给主治医生。
1、试管移植术后1-3天阴道出血
通常在这个阶段的出血,有可能是宫颈糜烂导致,或移植过程中宫颈黏膜轻微刺激后少量出血。准妈妈们不必紧张,休息几天出血就会消停。如果出血持续一周,就有必要就诊,查明出血原因了。

阴道出血是冻胚移植失败的前兆
2、试管移植术后7-14天阴道出血
这个阶段阴道少量出血不必紧张,继续保胎药物治疗即可,待到移植后10~14天来院抽血确认是否怀孕,之后医生会根据您的具体情况安排后续治疗方案。
3、试管移植术后14-28天阴道出血
如果血HCG确认怀孕,这个阶段出血阴道出血必须高度警惕宫外孕。如果B超检查提示宫内孕,则继续保胎治疗。
准妈妈在移植后要时刻关注身体的变化,一丁点的异常都有可能影响试管婴儿移植的效果。对于移植后常见的阴道出血现象,不必惊慌,从容面对。如有必要应立即就诊,确保胎儿的安全发育。
冻胚移植失败的征兆有哪些
很多人都比较关注试管移植失败的征兆,以此好尽早判断试管是否移植成功,其实无论是试管移植是否成功,每个人的症状上不同的,并且所谓的一些囊胚失败的前兆和鲜胚移植失败的症状仅仅是个例,不能套用在所有人身上。

冻胚移植失败了有哪些表现
移植后,女性的身体也会出现一系列的症状,比如腹痛、阴道出血、便秘等。但这些都只是移植试管后的表现,并不能说明是移植成功了还是失败了。
但如果女性在移植后的第十天开始,阴道每天都有流血,就像月经一样时,此时则可以考虑移植失败,需要尽快去医院进行确诊。如果是移植后,身体的不适已经影响到了正常的生活和休息,女性也应该去医院进行检查,看看胎儿是否发育正常。
导致试管移植失败的因素有很多种,常见的有女性年龄过大、子宫存在异常、染色体出现变异等。在做试管婴儿之前,应该将这些容易导致移植失败的因素做好排除,降低移植失败的概率。
热门关注
-

2026年舟山试管婴儿医院排名专栏,成功率+费用都在这里
舟山市隶属于浙江省,从卫健委公示的信息来看,目前舟山市能够进...
-

试管代生收费:阴道出血是试管婴儿移植失败前兆吗?
试管冻胚移植后很多准妈妈对于自身发生的一些变化异常关注,尤其...
-

2026浙江试管婴儿费用明细一览表,附浙江试管生男孩名单整理汇总
据统计数据显示,目前全球通过试管婴儿技术出生的宝宝已超过80...
-

专业试管供卵:浙江试管婴儿男孩子能生吗?去浙江做试管能做男孩吗?
浙江试管婴儿男孩子能生吗?去浙江做试管能做男孩吗?到2026...
-

代怀孕包出生:备孕期间用药了,会影响到宝宝吗?
优生优育的观念如今深入人心,每个在备孕中的朋友都希望以更好的...